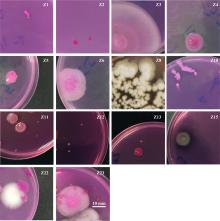

热带病与寄生虫学 ›› 2025, Vol. 23 ›› Issue (5): 289-295.doi: 10.20199/j.issn.1672-2302.2025.05.007
龙萍( ), 徐宁, 黄君慧, 王嘉敏, 朱李芸, 周雨, 公衍峰, 姜庆五, 周艺彪(
), 徐宁, 黄君慧, 王嘉敏, 朱李芸, 周雨, 公衍峰, 姜庆五, 周艺彪( )
)
收稿日期:2024-12-16
出版日期:2025-10-20
发布日期:2025-11-28
通信作者:
周艺彪,E-mail: z_yibiao@hotmail.com
作者简介:龙萍,女,硕士在读,研究方向:感染性疾病流行病学。E-mail: 基金资助:
LONG Ping( ), XU Ning, HUANG Junhui, WANG Jiamin, ZHU Liyun, ZHOU Yu, GONG Yanfeng, JIANG Qingwu, ZHOU Yibiao(
), XU Ning, HUANG Junhui, WANG Jiamin, ZHU Liyun, ZHOU Yu, GONG Yanfeng, JIANG Qingwu, ZHOU Yibiao( )
)
Received:2024-12-16
Online:2025-10-20
Published:2025-11-28
Contact:
ZHOU Yibiao,E-mail: z_yibiao@hotmail.com
摘要:
目的 了解钉螺体内可培养微生物群落结构特征,探讨环境pH值对钉螺体内可培养微生物的影响,为微生物灭螺提供参考。方法 野外采集钉螺,选择阴性成螺并随机分为中性组(A1组、A2组)、酸性组(B1组、B2组)、碱性组(C1组、C2组)和野外组(Y组),每组10只。A1组、B1组、C1组钉螺分别用去氯水(pH=7)、酸性培养液(pH=4)、碱性培养液(pH=10)饲养1周;A2组、B2组、C2组按上述条件饲养2周;Y组钉螺直接进行解剖。取钉螺软体组织制备菌悬液,分离培养需氧菌和真菌并进行菌落计数,运用Biolog微生物鉴定系统并结合显微镜染色观察鉴定微生物种类。结果 野外组(Y组)、中性组(A1组、A2组)、酸性组(B1组、B2组)、碱性组(C1组、C2组)共7组钉螺体内可培养菌落总数分别为(6.106±0.854)、(6.520±0.365)、(7.002±0.627)、(7.434±0.400)、(6.928±0.294)、(7.233±0.564)、(7.527±0.693)lg CFU/g,培养1周的碱性组(C1组)和酸性组(B1组)菌落总数高于中性组(A1组),培养2周的碱性组(C2组)的菌落总数高于中性组(A2组)和酸性组(B2组)(P均<0.05)。钉螺体内可培养的需氧菌共分离出7种,以小麦拉氏杆菌、水生黄杆菌和栖冷克吕沃尔菌为优势菌种;真菌共分离出14种,以新生隐球菌B、Trigonosporomyces hylophilus和白吉利丝孢酵母A为优势菌种。结论 从野外环境到实验室饲养环境,钉螺体内可培养的菌群结构会发生相应变化。碱性环境可以提高钉螺体内可培养需氧菌的多样性,但其对钉螺存活的生态学意义仍有待进一步阐明。
中图分类号:
龙萍, 徐宁, 黄君慧, 王嘉敏, 朱李芸, 周雨, 公衍峰, 姜庆五, 周艺彪. 环境pH值对钉螺体内可培养微生物影响的实验研究[J]. 热带病与寄生虫学, 2025, 23(5): 289-295.
LONG Ping, XU Ning, HUANG Junhui, WANG Jiamin, ZHU Liyun, ZHOU Yu, GONG Yanfeng, JIANG Qingwu, ZHOU Yibiao. Experimental study on the impact of environmental pH on culturable microorganisms in Oncomelania hupensis[J]. Journal of Tropical Diseases and Parasitology, 2025, 23(5): 289-295.
图3
钉螺体内可培养真菌菌落形态特征 注:Z1,中间白色外围深红色,圆形,光滑湿润,生长较慢,无菌丝,整体凸起;Z2,中间深红色外围白色,圆形,光滑湿润,生长较慢,无菌丝,中间凸起;Z3,中间红色外围白色,呈多个同心圆放射状展开,光滑湿润,生长快,有菌丝,平铺基面;Z4,中间红色外围白色,圆形,光滑湿润,生长快,无菌丝,平铺基面;Z5,中间红色外围白色,不规则近圆形,光滑湿润,生长快,无菌丝,中间凸起;Z6,中间红色外围白色,不规则近圆形,不光滑,干燥,生长快,无菌丝,中间凸起;Z8,中间白色外围灰青色,圆形,不光滑,干燥,生长慢,有菌丝,平铺基面;Z10,白色,圆形,不光滑,干燥,生长很慢,有菌丝,平铺基面;Z11,呈黄色、红色、白色同心圆自内到外展开,光滑湿润,生长快,无菌丝,中间凸起;Z12,淡红色,点状,光滑湿润,生长慢,无菌丝,中间凸起;Z13,中间深红色外围白色,若干个白色圆点散在分布,圆形,光滑湿润,生长较快,无菌丝,中间凸起;Z15,呈灰色、黑色、灰色同心圆从内到外展开,生长快,有菌丝,平铺基面;Z22,白色,圆形,不光滑,干燥,生长很快,有放射状的毛绒菌丝,平铺基面;Z23,中间红色外围白色,圆形,干燥,生长很快,有放射状的毛绒菌丝,平铺基面。

表3
钉螺体内可培养真菌的菌落分布情况(CFU)
| 组别 | Z1 | Z2 | Z3 | Z4 | Z5 | Z6 | Z8 | Z10 | Z11 | Z12 | Z13 | Z15 | Z22 | Z23 | 合计 |
|---|---|---|---|---|---|---|---|---|---|---|---|---|---|---|---|
| Y | 1 | 4 | 1 | 1 | 1 | 1 | 多* | 1 | 0 | 0 | 0 | 0 | 0 | 0 | — |
| A1 | 0 | 0 | 0 | 0 | 0 | 0 | 0 | 13 | 1 | 0 | 0 | 0 | 0 | 0 | 14 |
| B1 | 0 | 38 | 0 | 0 | 0 | 0 | 0 | 0 | 41 | 91 | 0 | 0 | 0 | 0 | 170 |
| C1 | 0 | 27 | 0 | 2 | 0 | 0 | 0 | 1 | 11 | 19 | 0 | 0 | 0 | 0 | 60 |
| A2 | 0 | 30 | 0 | 1 | 4 | 0 | 0 | 0 | 16 | 86 | 24 | 0 | 1 | 0 | 162 |
| B2 | 0 | 86 | 0 | 0 | 1 | 0 | 0 | 0 | 67 | 122 | 19 | 0 | 0 | 0 | 295 |
| C2 | 0 | 44 | 0 | 0 | 3 | 0 | 0 | 0 | 28 | 363 | 28 | 1 | 1 | 1 | 469 |
| [1] | 王鑫瑶, 张键锋, 郭家钢, 等. 凝练中国血吸虫病防控成功经验贡献于WHO指南在全球实施[J]. 中国血吸虫病防治杂志, 2022, 34(3):230-234,240. |
| [2] | 许静, 吕山, 曹淳力, 等. 我国血吸虫病消除工作进展及面临的挑战[J]. 中国血吸虫病防治杂志, 2018, 30(6):605-609. |
| [3] | 倪加加, 余育和, 胡合华, 等. 钉螺体内细菌群落结构PCR-DGGE分析方法的建立[J]. 四川动物, 2010, 29(5):546-549. |
| [4] | 董淑容, 姜杰, 王英鉴, 等. 东洞庭湖洲滩水体环境对钉螺体内微生物群落的影响[J]. 中国血吸虫病防治杂志, 2020, 32(2):132-139. |
| [5] | 陈祥麟. 凸形假单胞菌对钉螺的杀灭作用[J]. 微生物学通报, 1983, 10(5):215-217. |
| [6] | 董淑容. 东洞庭湖血吸虫中间宿主钉螺自然消亡与体内微生物的关系研究[D]. 上海: 复旦大学, 2020. |
| [7] | 郑华英, 成聪, 解春霞, 等. 灭钉螺微生物初步筛选试验[J]. 江苏林业科技, 2012, 39(1):21-24. |
| [8] | 国家卫生健康委员会,国家市场监督管理总局. 食品安全国家标准食品微生物学检验菌落总数测定:GB 4789. 2—2022[S]. 北京: 中国标准出版社, 2022. |
| [9] |
Wu JY, Zhou YB, Chen Y, et al. Three gorges dam: impact of water level changes on the density of schistosome-transmitting snail Oncomelania hupensis in Dongting Lake area, China[J]. PLoS Negl Trop Dis, 2015, 9(6):e0003882.
doi: 10.1371/journal.pntd.0003882 URL |
| [10] |
Yang Y, Gao JC, Cheng WT, et al. Three Gorges Dam: polynomial regression modeling of water level and the density of schistosome-transmitting snails Oncomelania hupensis[J]. Parasit Vectors, 2018, 11(1):183.
doi: 10.1186/s13071-018-2687-x pmid: 29540206 |
| [11] |
Gong YF, Tong YX, Jiang HL, et al. Three Gorges Dam: Potential differential drivers and trend in the spatio-temporal evolution of the change in snail density based on a Bayesian spatial-temporal model and 5-year longitudinal study[J]. Parasit Vectors, 2023, 16(1):232.
doi: 10.1186/s13071-023-05846-6 pmid: 37452398 |
| [12] | 何欢, 周金星, 高梓欣, 等. 长江滩地不同土地利用类型土壤微生物与理化性质及其对钉螺分布的影响[J]. 中国血吸虫病防治杂志, 2024, 36(2):148-153,200. |
| [13] | 程婉婷, 潘翔, 杨亚, 等. 东洞庭湖秋冬季节钉螺生存状态及其影响因素的研究[J]. 中国血吸虫病防治杂志, 2018, 30(1):18-21,36. |
| [14] | Wu JY, Zhou YB, Li LH, et al. Identification of optimum scopes of environmental factors for snails using spatial analysis techniques in Dongting Lake Region, China[J]. Parasit Vectors, 2014,7:216. |
| [15] | 李源培, 王海银, 周艺彪, 等. 湖区钉螺孳生地的微生态环境对钉螺分布的影响[J]. 中华流行病学杂志, 2010, 31(2):163-166. |
| [16] |
Nihei N, Kanazawa T, Blas BL, et al. Soil factors influencing the distribution of Oncomelania quadrasi, the intermediate host of Schistosoma japonicum, on Bohol Island, Philippines[J]. Ann Trop Med Parasitol, 1998, 92(6):699-710.
doi: 10.1080/00034983.1998.11813330 URL |
| [17] |
Posadas N, Baquiran JIP, Nada MAL, et al. Microbiome diversity and host immune functions influence survivorship of sponge holobionts under future ocean conditions[J]. ISME J, 2022, 16(1):58-67.
doi: 10.1038/s41396-021-01050-5 URL |
| [18] | Harrison XA, Price SJ, Hopkins K, et al. Diversity-stability dynamics of the amphibian skin microbiome and susceptibility to a lethal viral pathogen[J]. Front Microbiol, 2019,10:2883. |
| [19] | 杨苏声. 细菌分类学[M]. 北京: 中国农业大学出版社,1997. |
| [20] | 邵力平, 沈瑞祥, 张素轩, 等. 真菌分类学[M]. 北京: 中国林业出版社,1984. |
| [21] | 肖瑞芬, 杨建明, 汪平尧, 等. 自养黄色杆菌杀钉螺的实验研究[J]. 中国血吸虫病防治杂志, 2005, 17(1):42-44. |
| [22] | 赵劲松, 汪安云, 周书林. 长江滩地微生态环境与钉螺分布的关系[J]. 中国血吸虫病防治杂志, 2014, 26(2):127-131. |
| [23] | 魏凤华, 王汝波, 徐兴建, 等. 三峡建坝后血吸虫病传播危险因素研究Ⅰ库区生态环境变化对钉螺孳生可能性研究[J]. 中国血吸虫病防治杂志, 2007, 19(2):81-85,76. |
| [24] | 鲍沁露. 部分环境因子对湖北钉螺耗氧率、排氨率及呼吸相关酶活力的影响[D]. 芜湖: 皖南医学院, 2017. |
| [1] | 刘健, 唐雯茜, 林源, 蒋智华, 张伟尉, 吕国丽, 孟军, 唐咸艳. 2020—2024年广西壮族自治区血吸虫病监测结果分析[J]. 热带病与寄生虫学, 2025, 23(5): 268-272. |
| [2] | 单晓伟, 陈新苗, 肖瑛, 李凯杰, 陈艳艳, 刘斯, 刘建兵. 2015—2024年湖北省血吸虫病综合防治效果评估[J]. 热带病与寄生虫学, 2025, 23(5): 273-277. |
| [3] | 李敏洁, 吴毅强, 廖师夷, 杨宇哲, 洪钰婕, 谢云峰, 吴安云, 刘佳, 孙恩涛. 马六甲肉食螨成虫共生微生物多样性分析[J]. 热带病与寄生虫学, 2025, 23(5): 296-300. |
| [4] | 汪天平, 操治国. 安徽省实现消除血吸虫病的机遇、挑战与思考[J]. 热带病与寄生虫学, 2025, 23(1): 1-6. |
| [5] | 许月野, 许薇, 杨月阳, 张安胜, 杨志伟, 王广辉, 操治国, 赵金红. 钉螺体内吸虫尾蚴的形态和分子特征鉴定[J]. 热带病与寄生虫学, 2025, 23(1): 44-48. |
| [6] | 叶独秋, 张驰, 庞博文, 吴佳玲, 蒋露芳, 吕锡宏. 上海市松江区白纹伊蚊共生微生物宏基因组分析[J]. 热带病与寄生虫学, 2024, 22(6): 334-338. |
| [7] | 李春英, 崔晓, 杜春红, 王洪琼, 杨早改, 王云松, 宋静, 董毅. 微卫星和线粒体生物技术在湖北钉螺遗传分化研究中的应用[J]. 热带病与寄生虫学, 2024, 22(6): 375-381. |
| [8] | 吕超, 许晓娟, 杜春红, 张键锋, 李宜锋, 邓王平, 秦志强, 李石柱, 张世清, 许静. 《野鼠血吸虫感染情况监测工作方案(2024年版)》解读[J]. 热带病与寄生虫学, 2024, 22(4): 193-197. |
| [9] | 金伟, 张光明, 黄殷殷, 操治国, 汪天平. 《血吸虫病防治领域杀螺剂的室内和现场药效试验指南》摘译[J]. 热带病与寄生虫学, 2023, 21(6): 305-310. |
| [10] | 王晓艺, 杨江华. 血吸虫病与消化系统肿瘤关系的研究进展[J]. 热带病与寄生虫学, 2023, 21(6): 357-361. |
| [11] | 熊彦红, 曹建平, 郑彬. 寄生虫病原实验室生物安全风险评估规范化培训方案建立及探讨[J]. 热带病与寄生虫学, 2023, 21(5): 291-294. |
| [12] | 戴建军, 刘泽祥, 陈县, 柯永文, 龙道胜, 慈胜利. 2020—2022年池州市贵池区野鼠血吸虫感染调查结果分析[J]. 热带病与寄生虫学, 2023, 21(4): 228-231. |
| [13] | 张利娟, 李仕祯, 李银龙, 祝红庆, 曹淳力, 许静, 李石柱. 《血吸虫病消除推进试点县工作方案(2023年版)》解读[J]. 热带病与寄生虫学, 2023, 21(3): 121-125. |
| [14] | 张佳京, 徐明星, 罗华堂, 王浩, 李洋, 熊月琳, 王帅, 刘毅俊. 2016—2020年武汉市晚期血吸虫病死亡患者调查分析[J]. 热带病与寄生虫学, 2022, 20(6): 310-312,316. |
| [15] | 冯晓明, 柯永文, 刘泽祥, 戴建军, 李祥胜, 陈满红, 赵正斌. 2016—2021年池州市贵池区新发和复现钉螺情况分析[J]. 热带病与寄生虫学, 2022, 20(6): 321-324. |
| 阅读次数 | ||||||
|
全文 |
|
|||||
|
摘要 |
|
|||||